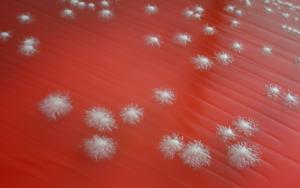

Microbiology
“Graduates can explore roles in research, quality control and compliance across healthcare, biotechnology and public health. They gain practical skills while advancing knowledge in biochemistry, molecular biology and statistics.”
Our Programmes
The subject Microbiology is a major in a variety of degree programmes offered by the Faculty of Science. Microbiology is the study of microscopically small organisms such as bacteria, archaea, viruses, fungi, prions, protozoa, and algae. Microbial activities and interactions are vitally important to virtually all processes on earth, playing key roles in nutrient cycling, biodegradation, climate change, food spoilage, as well as the cause and control of disease. The science of microbiology aims to gain and expand our fundamental understanding of microorganisms by studying their morphology, metabolism, physiology, reproduction and genetics, as well as their interactions with other organisms and their role in ecology. Together the subject areas of Biochemistry, Microbiology and Genetics form the core of Biotechnology. The following degree programmes have Microbiology as a major:
BSc Molecular Biology and Biotechnology
BSc Biodiversity and Ecology (Focal area: Plants and Microbes)
Our postgraduate programmes
BScHons in Microbiology
MSc in Microbiology
PhD in Microbiology
Upcoming Events
Attend our events for the opportunity to discover, grow, learn and engage with our community.